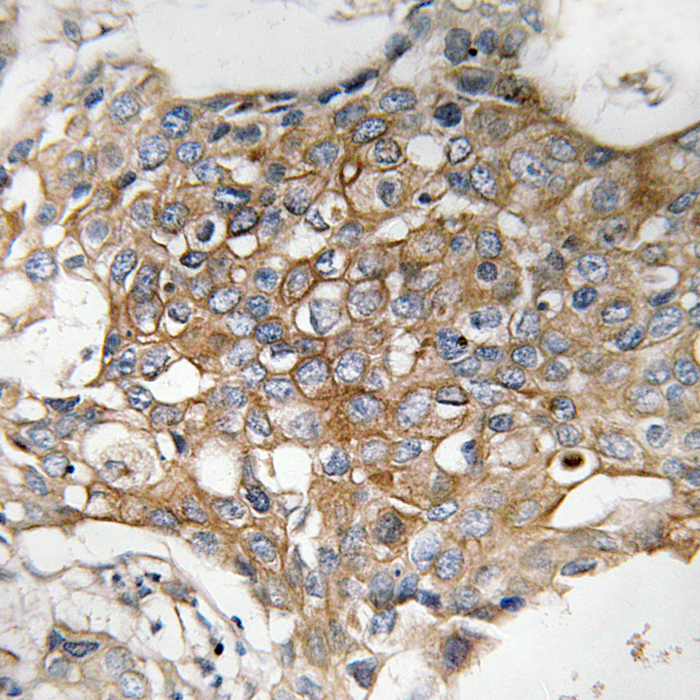
产品细节图片2

相关产品推荐更多 >
万千商家帮你免费找货
0 人在求购买到急需产品
- 详细信息
- 文献和实验
- 技术资料
- 免疫原:
KLH-conjugated synthetic peptide encompassing a sequence within the C-term region of human TMEM185A.
- 形态:
liquid
- 保存条件:
Store at -20˚C
- 克隆性:
Polyclonal
- 适应物种:
Human;Mouse
- 保质期:
12 months
- 抗原来源:
Rabbit
- 供应商:
南京赛戈巍生物科技有限公司
- 宿主:
Rabbit
- 应用范围:
WB IHC IF
- 靶点:
Uniprot:Q8NFB2
- 抗体英文名:
FAM11A Antibody
- 规格:
50ul/100ul
计算分子量:41KD
配方:Rabbit IgG in phosphate buffered saline (without Mg2+ and Ca2+), pH 7.4, 150mM NaCl, 0.02% sodium azide and 50% glycerol.
应用详情:Western blotting:1:500 - 1:1000
Immunohistochemistry:1:50 - 1:100
Immunofluorescence:1:100 - 1:300
图片:

Western blot analysis of LEKTI expression in HeLa whole cell lysates.
,
Immunohistochemical analysis of FAM11A staining in human breast carcinoma formalin fixed paraffin embedded tissue section. The section was then incubated with the antibody at room temperature and detected using an HRP conjugated compact polymer system. DAB was used as the chromogen. The section was then counterstained with haematoxylin and mounted with DPX.
,

Immunofluorescent analysis of FAM11A staining in MCF7 cells. Formalin-fixed cells were permeabilized with 0.1% Triton X-100 in TBS for 5-10 minutes and blocked with 3% BSA-PBS for 30 minutes at room temperature. Cells were probed with the primary antibody in 3% BSA-PBS and incubated overnight at 4 C in a hidified chamber. Cells were washed with PBST and incubated with Alexa Fluor 647-conjugated secondary antibody (red) in PBS at room temperature in the dark.
风险提示:丁香通仅作为第三方平台,为商家信息发布提供平台空间。用户咨询产品时请注意保护个人信息及财产安全,合理判断,谨慎选购商品,商家和用户对交易行为负责。对于医疗器械类产品,请先查证核实企业经营资质和医疗器械产品注册证情况。
 文献和实验
文献和实验FAM caspase 8 and 9 binding assay for embryos
The FAM caspase binding assay kits from ATCC Corporation can be used to determine amounts of active caspases in cells. The FAM-labeled caspase inhibitor can freely diffuse into the cell. Active caspase irreversibly binds the inhibitor.
DDS—11A型电导率仪是常用的电导率测量仪器。它除能测量一般液体的电导率外,还能测量高纯水的电导率,被广泛用于水质检测、水中含盐量、大气中SO 2 含量等的测定和电导滴定等方面。 以下介绍国产DDS—11A型电导率仪的使用。 1、按电导率仪使用说明书的规定选用电极,放在盛有待测溶液的烧杯中数分钟。 2、未打开电源开关前,观察表头指针是否指零。如不指零,可调整表头螺丝使指针指零。 3、将“校正、测量”开关
一、操作步骤1.接通电源前观察表头指针是否指零,若有偏差调节表头下方凹孔,使其恰指零。2.接通电源,仪器预热10分钟。3.将电极浸入被测溶液(或水)中,须确保极片浸没,将电极插头插入插座。4.调节“常数”钮,使其与电极常数标称值一致。例所用电极的常数为0.98,则把“常数”钮白线对准0.98刻度线。5.将“量程”置在合适的倍率档上,若事先不知被测液体电导率高低,可先置于较大的电导率档,再逐档下降,以防表头针打弯。6.将“校正-测量”开关置于“校正”位,调“校正”电位器使表针指满度值
 技术资料
技术资料暂无技术资料 索取技术资料





![CYP2W1 Polyclonal Antibody[49185]](https://img1.dxycdn.com/p/s14/2025/0922/632/2321321568067599691.jpg!wh200)
![UAP56 Antibody[35371]](https://img1.dxycdn.com/p/s14/2025/0922/359/6146153295428599691.jpg!wh200)
![TNFSF18 Polyclonal Antibody[42693]](https://img1.dxycdn.com/p/s14/2025/0922/568/0046652811090600791.jpg!wh200)
![Phospho-GluR1(S845) Rabbit mAb[13418]](https://img1.dxycdn.com/p/s14/2025/0923/496/0462304380155040791.jpg!wh200)
![NUCB2 Rabbit Polyclonal Antibody[53407]](https://img1.dxycdn.com/p/s14/2025/0922/498/0460884283108299691.jpg!wh200)
